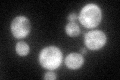
YIR026C
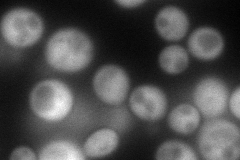
YIR026C
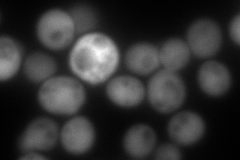
YIR026C
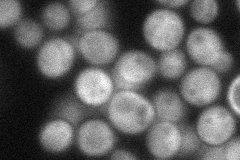
YIR026C

View description
Protein phosphatase involved in vegetative growth at low temperatures, sporulation, and glycogen accumulation; mutants are defective in 60S ribosome assembly; member of the dual-specificity family of protein phosphatases
Localization:
Intensity:
Fold change:
Significance:
-
C’ GFP library in SD
cytosol46.65 -
N' NOP1pr-GFP in SD
cytosol172.802 -
N' TEF2pr-mCherry in SD
cytosol225.508 -
N' NATIVEpr-GFP in SD
cytosol53.8203 -
N' TEF2pr-VC and Cyto-VN in SD

cytosol51.6474 -
C’ GFP library in SD+DTT

cytosolN/AN/ANo -
C’ GFP library in SD+H2O2

cytosol46.460.99No -
C’ GFP library in Starvation Media

cytosol40.330.86No -
C’ GFP library on the background of Pup2-DaMP

cytosol -
C’ GFP library on the background of CCT mutant

cytosol42.50750.911067No
